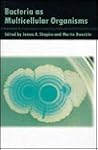
Bacteria as Multicellular Organisms

Goodreads helps you follow your favorite authors. Be the first to learn about new releases!
Start by following James A. Shapiro.
Showing 1-3 of 3
“For those scientists who take it seriously, Darwinian evolution has functioned more as a philosophical belief system than as a testable scientific hypothesis. This quasi-religious function of the theory is, I think, what lies behind many of the extreme statements that you have doubtless encountered from some scientists opposing any critical analysis of neo-Darwinism in the classroom. It is also why many scientists make public statements about the theory that they would not defend privately to other scientists like me.”
―
―
“There are no detailed Darwinian accounts for the evolution of any fundamental biochemical or cellular system, only a variety of wishful speculations
[Article : "In the Details . . . What?"]”
―
[Article : "In the Details . . . What?"]”
―
“Bacteria evolved mechanisms that could inactivate, block, or excrete various antibiotics. Moreover, bacteria transferred genetic determinants for these resistances between species and aggregated different resistances together on transmissible DNA elements known as resistance plasmids or R factors.”
― Evolution: A View from the 21st Century. Fortified.
― Evolution: A View from the 21st Century. Fortified.